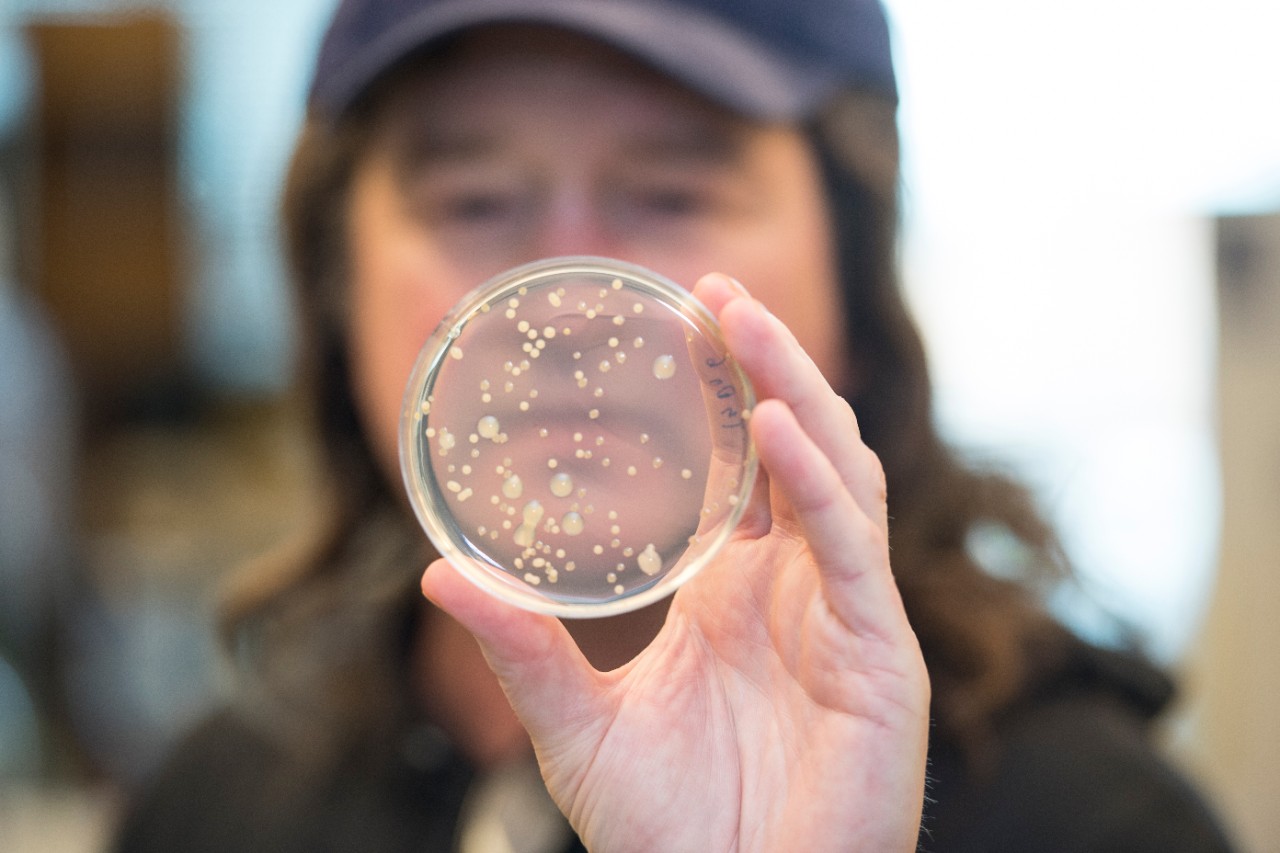
man holding petri dish

$1.2 million planned gift for research at UC College of Medicine
Local realtor passionate about treating cystic fibrosis
Cincinnati Realtor Julz Brown has created a $1.2 million planned gift to support research involving the treatment of pulmonary infections at the University of Cincinnati College of Medicine. The fund will be named after the late Mary Beth Comer, a family friend, who had cystic fibrosis (CF).
As a friend of the Comer family, Brown has been moved to see the deep family bond and continued dedication to local CF fundraising efforts. This sparked her interest in the disease and the desire to help find a treatment.
“While I did not know Mary Beth personally, I was deeply touched that her family has worked on fundraising efforts for more than 40 years,” she says. “It’s amazing when families pull together and this family is the epitome of heartwarming.”
She says it’s serendipitous to find someone working on innovative research in Cincinnati. Daniel Hassett, PhD, a professor in the UC College of Medicine’s Department of Molecular Genetics, Biochemistry, and Microbiology, has patented a potential treatment for pulmonary infection in patients with CF and chronic obstructive pulmonary disease (COPD). Finding his research both fascinating and hopeful, Brown says it made sense to help advance a timely treatment for a disease that impacted the Comer family.
I’m so impressed with Dr. Hassett’s work and I also know that science is impactful but also expensive. Not only does AB569 help those with CF, but other life-threatening conditions, making it an easy choice for me to support.
Julz Brown
“I’m at the point in my life where I can do something for someone else,” she says. “I think if 2020 showed us that we have to help each other.”
As a long-time resident of the university neighborhood, Brown has deep roots in Clifton and a strong affinity for UC. She notes that Mary Beth Comer was a UC graduate.
Hassett has developed and patented a novel antimicrobial drug called AB569 that is effective at killing antibiotic-resistant organisms (commonly referred to as “superbugs”). He’s made it his life’s goal to eradicate the bacteria that cause airway-related infections that occur with CF and COPD. His AB569 technology can also be used to treat wounds associated with burns, surgical incisions and diabetic skin ulcers, as well as problematic urinary tract infections. In March 2021, Arch Biopartners Inc., a Toronto-based publicly traded biotechnology company, announced that it entered into an exclusive agreement with UC to license patent claims for AB569.
“I’m so impressed with Dr. Hassett’s work and I also know that science is impactful but also expensive,” Brown says. “Not only does AB569 help those with CF, but other life-threatening conditions, making it an easy choice for me to support.”
Brown has set up a separate fund supporting Hassett’s research. Donations can be made online.
Featured image at top of Daniel Hassett/Colleen Kelley/UC Creative + Brand
Next, Now
With its focus on innovation and impact, Next, Now: The Campaign for Cincinnati is where ambition meets action. At the University of Cincinnati and UC Health, we’re driven by next; thinking bolder and dreaming bigger to create the tomorrow we envision, today. Learn more at nextnow.uc.edu.
Related Stories
Sugar overload killing hearts
November 10, 2025
Two in five people will be told they have diabetes during their lifetime. And people who have diabetes are twice as likely to develop heart disease. One of the deadliest dangers? Diabetic cardiomyopathy. But groundbreaking University of Cincinnati research hopes to stop and even reverse the damage before it’s too late.
App turns smartwatch into detector of structural heart disease
November 10, 2025
An app that uses an AI model to read a single-lead ECG from a smartwatch can detect structural heart disease, researchers reported at the 2025 Scientific Sessions of the American Heart Association. Although the technology requires further validation, researchers said it could help improve the identification of patients with heart failure, valvular conditions and left ventricular hypertrophy before they become symptomatic, which could improve the prognosis for people with these conditions.
Combination immunotherapy helps overcome melanoma treatment resistance
November 10, 2025
MSN highlighted research led by the University of Cincinnati Cancer Center's Trisha Wise-Draper showing a combination of immunotherapy medications can activate a robust immune response and help overcome treatment resistance in patients with refractory melanoma.
